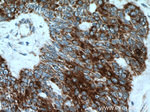
KRT34 Antibody in Immunohistochemistry (Paraffin) (IHC (P))

Search
Proteintech
KRT34 Polyclonal Antibody
{{$productOrderCtrl.translations['antibody.pdp.commerceCard.promotion.promotions']}}
{{$productOrderCtrl.translations['antibody.pdp.commerceCard.promotion.viewpromo']}}
{{$productOrderCtrl.translations['antibody.pdp.commerceCard.promotion.promocode']}}: {{promo.promoCode}} {{promo.promoTitle}} {{promo.promoDescription}}. {{$productOrderCtrl.translations['antibody.pdp.commerceCard.promotion.learnmore']}}
产品信息
20449-1-AP
种属反应
宿主/亚型
分类
类型
抗原
偶联物
形式
浓度
规格
纯化类型
保存液
内含物
保存条件
运输条件
产品详细信息
Immunogen sequence: WFCEGSFNG SEKETMQFLN DRLASYLEKV RQLERDNAEL EKLIQERSQQ QEPLLCPSYQ SYFKTIEELQ QKILCAKAEN ARLVVNIDNA KLASDDFRSK YQTEQSLRLL VESDINSIRR ILDELTLCKS DLESQVESLR EELICLKKNH EEEVNTLRSQ LGDRLNVEVD TAPTVDLNQV LNETRSQYEA LVETNRREVE QWFATQTEEL NKQVVSSSEQ LQSCQAEIIE LRRTVNALEI ELQAQHNLRD SLENTLTESE AHYSSQLSQV QSLITNVESQ LAEIRCDLER QNQEYQVLLD VRARLECEIN TYRSLLESED CKLPCNPCAT TNASGNSCGP CGTSQKGCCN (88-436 aa encoded by BC041070)
靶标信息
The protein encoded by this gene is a member of the keratin gene family. As a type I hair keratin, it is an acidic protein which heterodimerizes with type II keratins to form hair and nails. The type I hair keratins are clustered in a region of chromosome 17q12-q21 and have the same direction of transcription.
仅用于科研。不用于诊断过程。未经明确授权不得转售。
篇参考文献 (0)
生物信息学
蛋白别名: hair keratin; Hair keratin, type I Ha4; hard keratin, type I, 4; K34; keratin 34, type I; keratin complex 1, acidic, gene 4; keratin, hair, acidic, 4; Keratin, type I cuticular Ha4; Keratin-34; KRT hHa4; krt34
基因别名: 4733401E01Rik; Ha-4; Ha2; HA4; HHA4; HKA4; K34; Krt1-4; KRT34; KRTHA4
UniProt ID: (Human) O76011, (Mouse) Q9D646
Entrez Gene ID: (Human) 3885, (Mouse) 16672